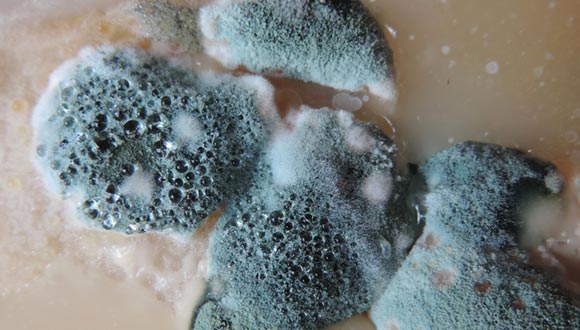
Mold inspection services from Stars and Stripes Home Inspections

Home Inspection Services
I have you covered with a variety of inspection services to meet your unique requirements.
I have you covered with a variety of inspection services to meet your unique requirements.
Are you looking for a full home inspection or something more specific? I have you covered with inspection services ranging from standard home inspections to 11th-month home warranty inspections, multi-unit housing inspections, manufactured home inspections, mold inspections, testing for radon gas, and more.
Gain greater peace of mind and clarity when buying a home, or ensure a smooth transaction with maximum return when selling your home.

Purchasing a new home also means buying that home's problems. With a pre-purchase home inspection you can see exactly what you're buying. Problems discovered during the inspection could allow you to renegotiate to offset the costs of repairs — potentially saving you thousands of dollars. I'll even help you become familiar with the property.

Sometimes selling your home can be just as much of a roller coaster as buying one. Getting a pre-listing home inspection can help ensure a quick and smooth transaction. You can enter the selling process with confidence that there won't be any unpleasant surprises. You'll also avoid delays, which could last for weeks or even months.

Unfortunately, new does not always mean perfect. In fact, new doesn't even guarantee good. Material defects and human error during the construction process can lead to expensive problems later on. A new construction home inspection can help identify these problems early, when they're cheaper to fix. Some issues may even be covered under warranty.

Don't release your builder from their warranty until you've had your home thoroughly examined by an experienced inspector. An end of home warranty inspection is a great opportunity to fix problems from faulty workmanship or materials — problems the builder should be accountable for. Many items I find are difficult to notice and could become a major safety or financial concern over time, leaving you to deal with the mess.

An annual home maintenance inspection will help to identify potential problems before they can become major financial or safety issues. With a trained eye, I know where and how to look for problems that might go unnoticed for years. A home maintenance inspection covers common problem areas including the roof and attic, basement and foundation, grading and drainage, electrical systems, water heating systems, and much more.

Radon is a naturally produced, radioactive gas — and the second leading cause of lung cancer, behind cigarettes. Radon gas can enter your home through the foundation and collect in the basement. A radon test will help to protect your family by checking for hazardous concentrations. If levels are too high, then a radon mitigation system should be installed.
Some mold growth can be toxic, and mold spores can cause symptoms of mold exposure in some people. A mold inspection will tell you if your home has a mold problem, and identify the moisture source that is causing it. If you are selling your home, then it's important to have your home pre-inspected for mold to avoid delays for remediation, which could take a month or longer.

Looking to buy an investment property with up to four separate units? I'll show you the current state of the property along with any needed repairs. The items covered in a multi-unit inspection are similar to a standard home inspection, with pricing depending on the size of the property. Get in touch with me for more information.

Avoid disputes with the landlord by having me inspect your rental unit, documenting the current state of the unit at the time of move-in. When you move out, an unscrupulous landlord will be unable to hold you financially accountable for problems that existed before you moved in.

A mobile or manufactured home is inspected in much the same way as a standard home inspection. However, these factory-built homes come with their own unique problems. I will perform a thorough inspection to look for additional, potentially costly, issues such as misaligned connections, improperly installed moisture barriers, and sagging of the structure.
Check faucets and showers, looking for visible leaks as well as testing water pressure. Identify the types of pipes used, if visible. Identify the location of the main water shutoff valve.
Identify the type of wiring, test a representative number of outlets, and make sure there are GFCIs installed where needed to protect from electrical shock. Inspect the electrical panel for safety issues and fire hazards.
Determine the approximate age of the furnace and air conditioner, whether or not they function properly, and possibly recommend repairs or maintenance.
Determine the approximate age of the water heater and check for proper installation. I can also determine the condition and possibly give an estimated remaining life span of the unit.
Check for proper ventilation. A poorly ventilated dryer exhaust can be a serious fire hazard.
Test smoke detectors and ensure that the garage wall, if present, has the proper fire rating and is undamaged. Also check the fireplace for proper installation and maintenance.
Check for visible leaks, properly secured toilets, proper ventilation to prevent moisture related issues, and more.
If possible, check for structural damage and proper ventilation. Also check insulation and ensure that nothing is ventilated directly into the attic, such as the bathroom.
Check for damaged or missing siding, cracks, and excessive soil contact which can be an invitation for pests.
Check for possible foundation failure, indicated by cracks or settling.
Check to ensure that the ground slopes away from the house, which prevents water from entering the house or causing damage to the foundation.
If accessible and visible, check for roof damage or poor installation that may allow for water penetration as well as checking the condition of the gutters.
Test the garage door for proper functionality, check for proper ventilation to prevent carbon monoxide poisoning, and check for risks of explosion from ignition sources too close to the floor.
Stars and Stripes Home Inspections provides professional home inspection services in the Triangle and Sandhill regions including Raleigh, Durham, Chapel Hill, Cary, Apex, Morrisville, Holly Springs, Fuquay-Varina, Southern Pines, Pinehurst, Aberdeen, Carthage, Fayetteville, Sanford, Lillington, and surrounding communities. Not sure if that's you? Give me a call at (910) 583-8501 or send me an email.